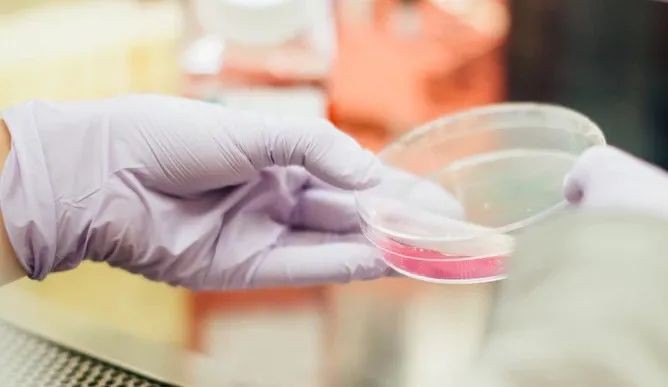
新增X，累计X万 | 制造业下周二逐步复工，新加坡经济砥砺前行

制造业下周二逐步复工,新加坡经济砥砺前行
截至今天(5月4日)中午12时,新加坡新增573新冠病例,累计18778例。新增病例多数是住在客工宿舍的工作准证持有者,5人为本地公民和永久居民。卫生部将在今晚公布确诊病例详情。
让我们先来回顾下昨天的疫情,昨天新加坡新增657例确诊,累计确诊人数为18205人。
 (本文截稿时,由于五国数据和新加坡当日数据细节:出院、ICU、转方舱、病亡人数、人员分布等,尚未齐全,因此有所滞后,感谢谅解。)另外,新加坡有61人病愈出院,累计出院人数为1408人。有22人在加护病房。
(本文截稿时,由于五国数据和新加坡当日数据细节:出院、ICU、转方舱、病亡人数、人员分布等,尚未齐全,因此有所滞后,感谢谅解。)另外,新加坡有61人病愈出院,累计出院人数为1408人。有22人在加护病房。  住在大型集体宿舍的客工确诊昨增626例。
住在大型集体宿舍的客工确诊昨增626例。  昨天新增病例中,有13例属于社区感染病例,其中10人是公民和永久居民,3人是长期准证持有者。另,有18人是不住宿舍的WP。
昨天新增病例中,有13例属于社区感染病例,其中10人是公民和永久居民,3人是长期准证持有者。另,有18人是不住宿舍的WP。 注:新加坡卫生部解释,“社区传播“之所以细分为WP和非WP(如公民与PR等),主要是后者是家庭传播为主,前者则可能是工作场所传播,政府为了观察和追查病毒传播模式,所以加以细分。卫生部表示,本地社区感染病例逐渐减少,从每日平均新增21起减至过去七天平均每日新增11起。感染源不明的社区感染病例也下跌,从每日新增13起减至过去七天平均每日新增五起。昨天新增一名新冠死亡病例,累计死亡18起。死者是一名86岁新加坡籍病患。她是第14744起病例,她是在4月27日确诊,确诊期间在邱德拔医院治疗,她生前有糖尿病、高血压和高脂血的病史。之前的新冠死者年龄介于64岁至95岁,生前大多患有慢性疾病。新加坡昨天也出现新加坡博览中心社区护理设施的保健促进局护士确诊。该护士是一名34岁新加坡籍女子,于昨日确诊,感染源不明。她近期没到过受疫情影响的国家和地区,目前在国家传染病中心接受治疗。
注:新加坡卫生部解释,“社区传播“之所以细分为WP和非WP(如公民与PR等),主要是后者是家庭传播为主,前者则可能是工作场所传播,政府为了观察和追查病毒传播模式,所以加以细分。卫生部表示,本地社区感染病例逐渐减少,从每日平均新增21起减至过去七天平均每日新增11起。感染源不明的社区感染病例也下跌,从每日新增13起减至过去七天平均每日新增五起。昨天新增一名新冠死亡病例,累计死亡18起。死者是一名86岁新加坡籍病患。她是第14744起病例,她是在4月27日确诊,确诊期间在邱德拔医院治疗,她生前有糖尿病、高血压和高脂血的病史。之前的新冠死者年龄介于64岁至95岁,生前大多患有慢性疾病。新加坡昨天也出现新加坡博览中心社区护理设施的保健促进局护士确诊。该护士是一名34岁新加坡籍女子,于昨日确诊,感染源不明。她近期没到过受疫情影响的国家和地区,目前在国家传染病中心接受治疗。 (图源:谷歌地图)新加坡昨日增6个新感染群,都在工业区: 位于宏茂桥62街(Ang Mo Kio Street 62)5号的NCS中心:3人 繁荣路(Fan Yoong Road)16号:9人 卡尔大道(Gul Way)15号:11人 双溪加株2街(Sungei Kadut Street 2)23号:29人 科技园弯(Tech Park Crescent)9A号:24人 兀兰E9工业园(Woodlands Industrial Park E9)64号:11人
(图源:谷歌地图)新加坡昨日增6个新感染群,都在工业区: 位于宏茂桥62街(Ang Mo Kio Street 62)5号的NCS中心:3人 繁荣路(Fan Yoong Road)16号:9人 卡尔大道(Gul Way)15号:11人 双溪加株2街(Sungei Kadut Street 2)23号:29人 科技园弯(Tech Park Crescent)9A号:24人 兀兰E9工业园(Woodlands Industrial Park E9)64号:11人  新加坡政府将从下周二(5月12日)逐步重启制造业活动,尽本份维持全球供应链,尤其生物医药、化工和精密工程,确保新加坡继续同世界经济接轨。
新加坡政府将从下周二(5月12日)逐步重启制造业活动,尽本份维持全球供应链,尤其生物医药、化工和精密工程,确保新加坡继续同世界经济接轨。  (图源:Unsplash) 随着新加坡逐步重启经济活动,从5月12日起,更多来自生物医药等的制造业人员将能复工,产能将提高。不过根据贸工部长陈振声在脸书发布的贴文,复工的这些公司,必须尽快做好各种预防措施准备,始制定分组办公、安全休息区,并利用科技追踪。以便在符合当局条件和批准后,员工才能回返工作场地,企业迅速恢复运营。
(图源:Unsplash) 随着新加坡逐步重启经济活动,从5月12日起,更多来自生物医药等的制造业人员将能复工,产能将提高。不过根据贸工部长陈振声在脸书发布的贴文,复工的这些公司,必须尽快做好各种预防措施准备,始制定分组办公、安全休息区,并利用科技追踪。以便在符合当局条件和批准后,员工才能回返工作场地,企业迅速恢复运营。 (图源:Unsplash)现在除了医疗人员,其他高风险群员工,例如那些同公众频密接触的前线人员,也需接受冠病检测。根据此次复工情况,政府将作出评估,如果“断路器”阻断措施可以顺利在6月1日结束,可考虑进一步开放其他行业的经济活动,但一些社交和娱乐场所暂时不开放,至于那些可以继续在家远程上班的员工,很可能需要继续远程上班。 陈振声指出,政府会在允许制造业更多工作场所开放之前,与商团商会密集合作,以确保各个行业的员工工作时都能保持安全距离等。
(图源:Unsplash)现在除了医疗人员,其他高风险群员工,例如那些同公众频密接触的前线人员,也需接受冠病检测。根据此次复工情况,政府将作出评估,如果“断路器”阻断措施可以顺利在6月1日结束,可考虑进一步开放其他行业的经济活动,但一些社交和娱乐场所暂时不开放,至于那些可以继续在家远程上班的员工,很可能需要继续远程上班。 陈振声指出,政府会在允许制造业更多工作场所开放之前,与商团商会密集合作,以确保各个行业的员工工作时都能保持安全距离等。  (图源:新加坡人力部脸书)他说复工员工必须遵守人际距离纪律,例如午餐时间或放工后必须避免社交活动。截止目前,政府没有透露制造业复工人数或比率。陈振声也透露,新加坡正在与韩国、澳大利亚、新西兰、加拿大和日本等国商议,讨论放宽有必要跨国出差员工的出行限制,制定边境健康检查和追踪感染者等程序。这些系统和筹备工作在进行中。
(图源:新加坡人力部脸书)他说复工员工必须遵守人际距离纪律,例如午餐时间或放工后必须避免社交活动。截止目前,政府没有透露制造业复工人数或比率。陈振声也透露,新加坡正在与韩国、澳大利亚、新西兰、加拿大和日本等国商议,讨论放宽有必要跨国出差员工的出行限制,制定边境健康检查和追踪感染者等程序。这些系统和筹备工作在进行中。
新加坡眼评论
新加坡经济为以服务业为主,服务业占新加坡名义GDP近70%,制造业占20.9%,建筑业占3.7%,。 对新加坡来说,制造业十分重要,表现在以下三点:一、制造业是GDP中比重最大的领域,它雇用了12.8%劳动力。建筑业则是12.1%。二、制造业对GDP其他领域如金融与保险、交通与仓储、商业服务、水电与能源等都有推动作用。3月7日,东南亚最大船运业者之一的新加坡太平船务集团执行主席张松声接受《联合早报》采访,他说 “过去两三个星期,我们的船停在港口却没货可载。因为不少工厂还没复工,即便复工了,货物也不一定运得出来。”三、在全球化背景下,新加坡制造业是全球供应链的一部分, 疫情打乱甚至打断了全球供应链,货品和服务需求下降,物流受到干扰使得商家无法按照合约规定日期交货。供应链一旦被受影响,上中下游断裂,无论缺了哪个环节都无法产出产品。因此,必须尽可能维护供应链和运输的开放互通,减少疫情对必需品流通的干扰,保障世界经济稳定有序地运行。一个例子是石油化工,新加坡是亚洲的石油业枢纽,也是世界三大出口炼油中心之一,其他如电子、医疗与医药等也是全球供应链的一部分,而这些恰恰是抗疫防疫物资最需要的领域。制造业停工,并不是“停两个月就可以一切如常了”这么简单。现在疫情在全球爆发,此起彼伏,不可能所有经济体的制造业一起“停两个月”,如果非要停工,一定是各自按照自己的抗疫日程停工,我们可以想象:A停工,B不停,但B的上游是A,B取不到原料,无法生产;等B取得A原料时,B生产出来的半成品给了C,但此时轮到C停工了,所以仍是无法生产出来;由于C无法生产,因此不会继续向B采购半成品,B也不会向A采购原料,这时尽管A已经复工,但只能望“机”兴叹。所以,在尽可能保证安全和健康的条件下逐步复工,尽可能维持全球供应链不断裂,是不少国家的共识。
对新加坡来说,制造业十分重要,表现在以下三点:一、制造业是GDP中比重最大的领域,它雇用了12.8%劳动力。建筑业则是12.1%。二、制造业对GDP其他领域如金融与保险、交通与仓储、商业服务、水电与能源等都有推动作用。3月7日,东南亚最大船运业者之一的新加坡太平船务集团执行主席张松声接受《联合早报》采访,他说 “过去两三个星期,我们的船停在港口却没货可载。因为不少工厂还没复工,即便复工了,货物也不一定运得出来。”三、在全球化背景下,新加坡制造业是全球供应链的一部分, 疫情打乱甚至打断了全球供应链,货品和服务需求下降,物流受到干扰使得商家无法按照合约规定日期交货。供应链一旦被受影响,上中下游断裂,无论缺了哪个环节都无法产出产品。因此,必须尽可能维护供应链和运输的开放互通,减少疫情对必需品流通的干扰,保障世界经济稳定有序地运行。一个例子是石油化工,新加坡是亚洲的石油业枢纽,也是世界三大出口炼油中心之一,其他如电子、医疗与医药等也是全球供应链的一部分,而这些恰恰是抗疫防疫物资最需要的领域。制造业停工,并不是“停两个月就可以一切如常了”这么简单。现在疫情在全球爆发,此起彼伏,不可能所有经济体的制造业一起“停两个月”,如果非要停工,一定是各自按照自己的抗疫日程停工,我们可以想象:A停工,B不停,但B的上游是A,B取不到原料,无法生产;等B取得A原料时,B生产出来的半成品给了C,但此时轮到C停工了,所以仍是无法生产出来;由于C无法生产,因此不会继续向B采购半成品,B也不会向A采购原料,这时尽管A已经复工,但只能望“机”兴叹。所以,在尽可能保证安全和健康的条件下逐步复工,尽可能维持全球供应链不断裂,是不少国家的共识。 三月份,新加坡出口开始受疫情影响。在新加坡的十大贸易伙伴中,三月份对中国大陆、印尼、马来西亚的非石油出口都出现负增长。
三月份,新加坡出口开始受疫情影响。在新加坡的十大贸易伙伴中,三月份对中国大陆、印尼、马来西亚的非石油出口都出现负增长。 (图源:新加坡企业发展局)由于马来西亚从3月18日开始执行行动管制令,当月新加坡出口即刻下跌。然而,从出口额来说,新加坡3月份非石油国内出口(NODX)比去年同期增长17.6%。这个数据看起来很美,其实是因为去年同期数据差(-11.7%),所以数据看来不错。
(图源:新加坡企业发展局)由于马来西亚从3月18日开始执行行动管制令,当月新加坡出口即刻下跌。然而,从出口额来说,新加坡3月份非石油国内出口(NODX)比去年同期增长17.6%。这个数据看起来很美,其实是因为去年同期数据差(-11.7%),所以数据看来不错。 (图源:新加坡企业发展局)出口与造业息息相关。同期,新加坡制造业增长16.5%。增长主要由生物医药业(3月产值同比飙涨91.4%)带动。如果不包括生物医药,3月产值则持平。经季节性调整后,3月制造业产值环比上升21.7%。不包括生物医药,则环比增长2.5%。
(图源:新加坡企业发展局)出口与造业息息相关。同期,新加坡制造业增长16.5%。增长主要由生物医药业(3月产值同比飙涨91.4%)带动。如果不包括生物医药,3月产值则持平。经季节性调整后,3月制造业产值环比上升21.7%。不包括生物医药,则环比增长2.5%。 (图源:新加坡经济发展局)生物医药业产值3月强劲飙涨,主要是不同活性药物成分组合和生物制品产量激增,使得药剂业产值大幅提高126.6%,而医疗设备出口需求增加,也使得医药科技领域产值上升6.3%。尽管3月产值并未凸显2019冠状病毒疾病疫情带来的重大影响,由于新加坡自4月7日起实施病毒阻断措施,预期冠病疫情冲击可能在4月份浮现。全年来看,由于全球疫情严重,全球供应链受损,新加坡今年制造业和出口肯定萎缩。这也是政府一早就呼吁企业尽可能不裁员的主要原因。每家企业都想做大做强,都想挣大钱。关键是,怎么样才能不裁员。在力保安全和健康的情况下,尽可能保持产量和产能,尽可能维持全球供应链不断裂,尽可能保持企业现金流不断裂,也许是没有办法中的办法。
(图源:新加坡经济发展局)生物医药业产值3月强劲飙涨,主要是不同活性药物成分组合和生物制品产量激增,使得药剂业产值大幅提高126.6%,而医疗设备出口需求增加,也使得医药科技领域产值上升6.3%。尽管3月产值并未凸显2019冠状病毒疾病疫情带来的重大影响,由于新加坡自4月7日起实施病毒阻断措施,预期冠病疫情冲击可能在4月份浮现。全年来看,由于全球疫情严重,全球供应链受损,新加坡今年制造业和出口肯定萎缩。这也是政府一早就呼吁企业尽可能不裁员的主要原因。每家企业都想做大做强,都想挣大钱。关键是,怎么样才能不裁员。在力保安全和健康的情况下,尽可能保持产量和产能,尽可能维持全球供应链不断裂,尽可能保持企业现金流不断裂,也许是没有办法中的办法。




















评论